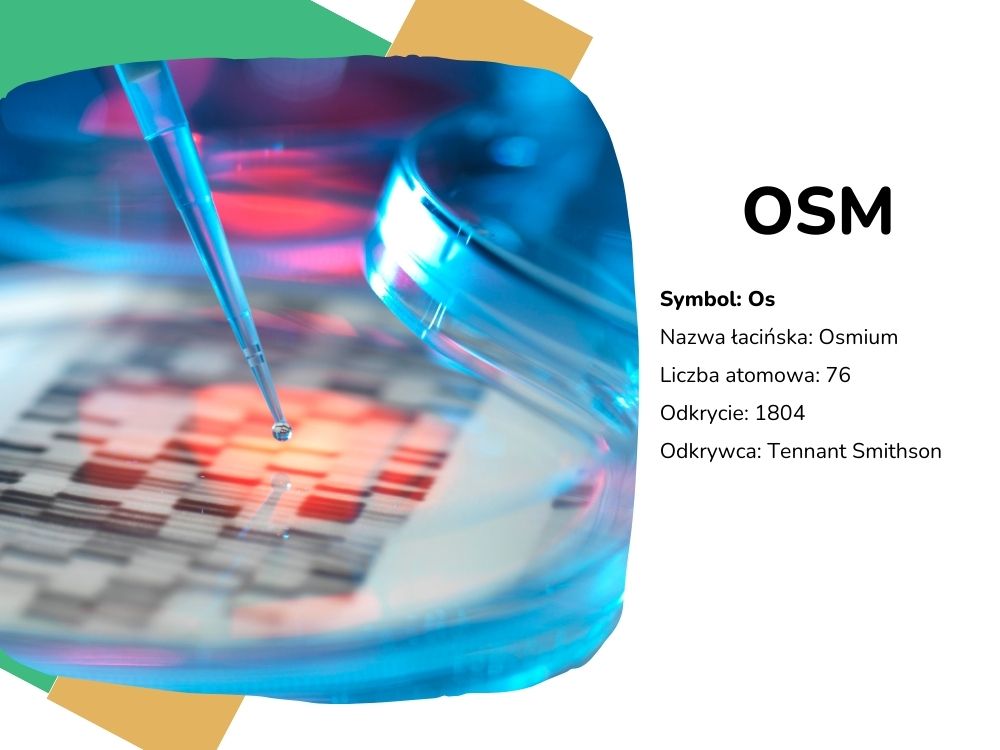
układ okresowy pierwiastków

Osm
Witaj! Cieszę się, że jesteś gotowy na kolejną fascynującą podróż po świecie pierwiastków. Przedstawiam Ci osm – rzadki i cenny pierwiastek, który kryje wiele tajemnic.
Sprawdź, gdzie znajdziesz ten pierwiastek w Układzie Okresowym Pierwiastków:

Historia odkrycia osmu
Osm został odkryty w 1803 roku przez angielskiego chemika Smithsona Tennanta podczas analizy minerałów platyny. Nazwa „osm” pochodzi od greckiego słowa „osme”, które oznacza „zapach”. Tennant nadał mu tę nazwę ze względu na nieprzyjemny zapach, jaki wydzielał osmowy tlenek.
Jak jest zbudowany atom osmu?
Atom osmu ma złożoną budowę, składającą się z 76 protonów, 114 neutronów i 76 elektronów. Jest to jeden z cięższych pierwiastków występujących w naturze. Osm należy do grupy metali przejściowych i ma wiele interesujących właściwości chemicznych.
Zastosowanie osmu w codziennym życiu
Osm ma wiele zastosowań w różnych dziedzinach nauki i technologii. Oto kilka przykładów:
Materiały wytrzymałe na korozję: Ze względu na swoją odporność na korozję, osm jest stosowany w produkcji różnych przedmiotów, takich jak elektrody, sprężyny czy narzędzia chirurgiczne.
Przemysł chemiczny: Osmowy tlenek jest wykorzystywany w produkcji barwników, farb i klejów. Ma także zastosowanie w syntezie organicznej i katalizatorach.
Narzędzia pisarskie: Dzięki swojej twardości i wytrzymałości, osm był wykorzystywany w przeszłości do produkcji stalowych piór do pisania.
Badania naukowe: Osm, ze względu na swoje unikalne właściwości chemiczne, jest szeroko wykorzystywany w badaniach naukowych, zwłaszcza w dziedzinie chemii nieorganicznej i biochemii.
Osm to pierwiastek, który pomaga nam lepiej zrozumieć świat wokół nas. Jego niezwykłe właściwości i różnorodne zastosowania czynią go niezwykle interesującym. Kontynuuj swoją przygodę z odkrywaniem świata pierwiastków i zanurz się w fascynującym świecie osmu!